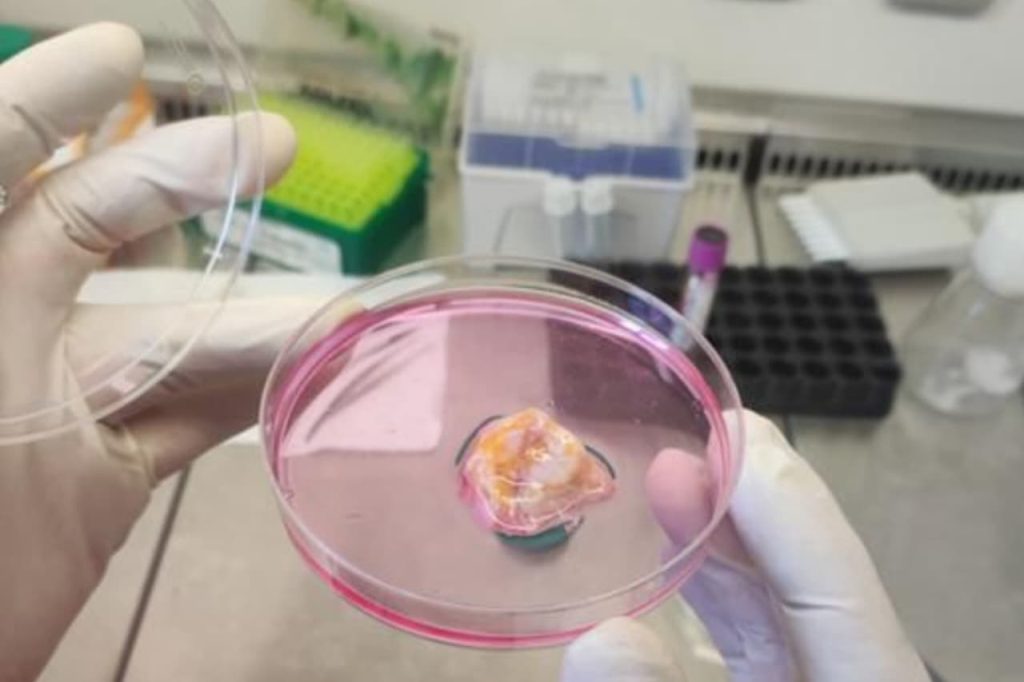
TILs Cancer Therapy

From urban centres to rural villages, people in Bangladesh are adopting digital finance at a pace unimaginable just a few years ago, and all of this is possible because mobile banking apps, which did not exist 15 years ago, are now commonplace. Millions of people are now able to manage their money by using their phones within seconds rather than travelling to a bank or a local money transfer service company. This article examines the top 5 mobile banking apps in Bangladesh, pointing out features and key differentiating factors that are relevant to all of the Mobile Banking Apps in the economy of 2025.
1. bKash – The King of Mobile Transactions
To dip your toe in the water of mobile banking features in Bangladesh is to start with bKash, which is the overall leader in usage of transactions among the platforms in Bangladesh. That includes their extensive agent network, which is used by people to transact all of their banking needs (sending money, receiving money, paying bills, even recharging (mobile) phones) and even putting their money away for saving or micro-loans. bKash’s strength is going to be trust and accessibility, meaning they are not the only one of the 5 fintech platforms mentioned above to reach rural communities.
They also currently integrate QR payments and merchant applications into their overall offering to cater to the regular user who comes across small daily purchases.
2. Nagad – Fast, Affordable, and Growing Quickly
Nagad, which is backed by the Bangladesh Post Office, is a real contender to bKash. It attracts users with lower service fees, offers cashback, and fast, digital KYC onboarding. Users can use QR for payment and easily transfer funds between them through the app.
If you are seeking a combination of modern features and affordability, Nagad is a flexible fit for innovation and savings.
3. Rocket – The Bank-Led Dependable Option
Rocket, which is powered by Dutch-Bangla Bank Limited, has the most seamless banking integration of all the options. Users can send funds expressly to, or from, their bank account, pay bills, and even withdraw cash from the DBBL ATM without a card.
So, if you would like a similar relationship of a more traditional bank with a mobile twist, Rocket is a solid option.
4. Upay – The Kinesthetic Fintech Interface
Upay is developed by United Commercial Bank Limited and is smooth in terms of interface, including seamless QR payments, merchant delivery, and low-cost transaction fees.
If you value design and smooth finishing in payments, Upay is becoming a solid choice in the fintech options.
5. SureCash – The Informed Payment Choice
With plenty of options available, SureCash is lesser known than bKash or Nagad, but is synonymous with educational payment, merchant solutions, and bill payments. SureCash’s close relationships with educational institutions and service providers set them apart.
SureCash is specialises in providing convenience for its targeted market segments: students, small businesses, and families with day-to-day purchases.
Final Thoughts
The top 5 digital payment apps in Bangladesh (bKash, Nagad, Rocket, Upay, SureCash) have presented opportunities for millions of people to access financial products. Each app has a very unique selling proposition: bKash has reach, Nagad has lower fees, Rocket has banking integrations, Upay has ease of use, and SureCash has educational payments.
Choose one that fits your needs – and participate in the coming digital economic revolution that will complement Bangladesh’s financial future.
Read Also: Best Time to Visit the Sundarbans from Barishal